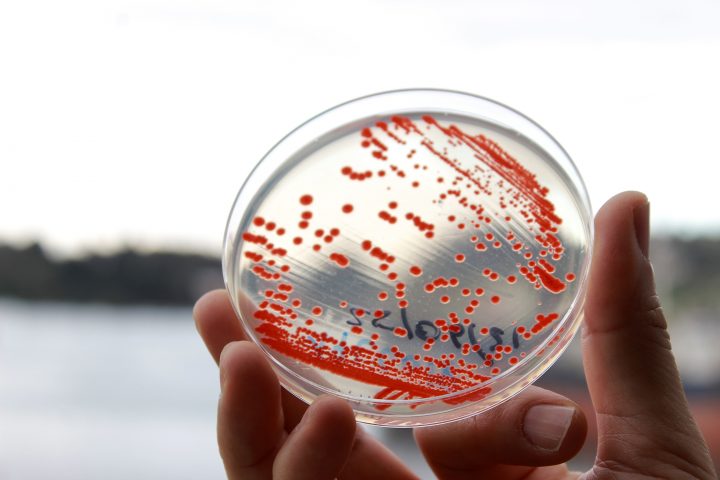

Universidad de Los Lagos impulsa la ciencia regional con proyecto FIU-T por más de $20 mil millones
Tiempo de lectura: 2 minutos La iniciativa busca consolidar a la casa de estudios como un polo de investigación aplicada, vinculando el conocimiento académico con las necesidades productivas del territorio en un horizonte de diez años.
La Universidad de Los Lagos (ULagos) lanzó oficialmente el proyecto Fondo I+D+i Universitario Territorial (FIU-T). Este plan de desarrollo contempla una inversión superior a los 20 mil millones de pesos, destinados a fortalecer la investigación regional y la transferencia tecnológica.
«La Universidad está al servicio del territorio y hoy somos una institución compleja y relevante para el desarrollo regional», afirmó el rector de la ULagos, Óscar Garrido, destacando que el proyecto permitirá articular de manera más eficiente las capacidades de la academia con el sector productivo local.
El proyecto FIU-T es la base del Plan Estratégico 2026-2035 de la universidad. Con recursos aportados conjuntamente por el Gobierno Regional y la propia Universidad de Los Lagos, esta iniciativa busca asegurar la sostenibilidad de las capacidades de Investigación, Desarrollo, Innovación y Creación (I+D+i+c) en la zona.

Un plan estratégico a diez años: 2026-2035
El doctor Hans Richter, vicerrector de Investigación, Innovación y Creación de la ULagos y director del proyecto, entregó cifras que justifican esta inversión. «La Universidad de Los Lagos concentra el 54% de la matrícula universitaria de la región y genera el 47,3% de la producción científica local, siempre con el foco puesto en las problemáticas del territorio. Con el FIU-T, queremos instalar capacidades estructurales que trasciendan el tiempo», explicó Richter.
Este programa, impulsado por el Ministerio de Ciencia, Tecnología, Conocimiento e Innovación, tiene como objetivo elevar la competitividad territorial a través de la gestión del conocimiento. En este sentido, el financiamiento permitirá no solo mantener las líneas de investigación actuales, sino también crear nuevas infraestructuras y procesos de gestión que faciliten la llegada de la ciencia a la industria y la comunidad.
Impacto en la infraestructura y el capital humano regional
La adjudicación del FIU-T fue recibida con entusiasmo por las autoridades regionales. La doctora Sandra Orellana, seremi de Ciencia de la Macrozona Sur, destacó que la Región de Los Lagos lidera el número de empresas de base científico-tecnológica a nivel nacional, lo que hace urgente contar con conocimiento aplicado de calidad. «Este proyecto consolida las capacidades de infraestructura, transferencia tecnológica y capital humano regional», enfatizó.
Por su parte, la vicerrectora del Campus Puerto Montt, Anita Dörner, puso el foco en el equipamiento científico que llegará a la capital regional. Según Dörner, los recursos permitirán complejizar la investigación interdisciplinaria y mejorar significativamente las instalaciones de Chinquihue y otras sedes.
«Celebramos esta adjudicación con altura de miras, porque posibilitará la disposición de equipamiento de vanguardia para realizar un trabajo coordinado. Esto es el resultado de un esfuerzo colectivo entre diversas direcciones de la universidad para elaborar un proyecto de alta calidad», concluyó la vicerrectora.